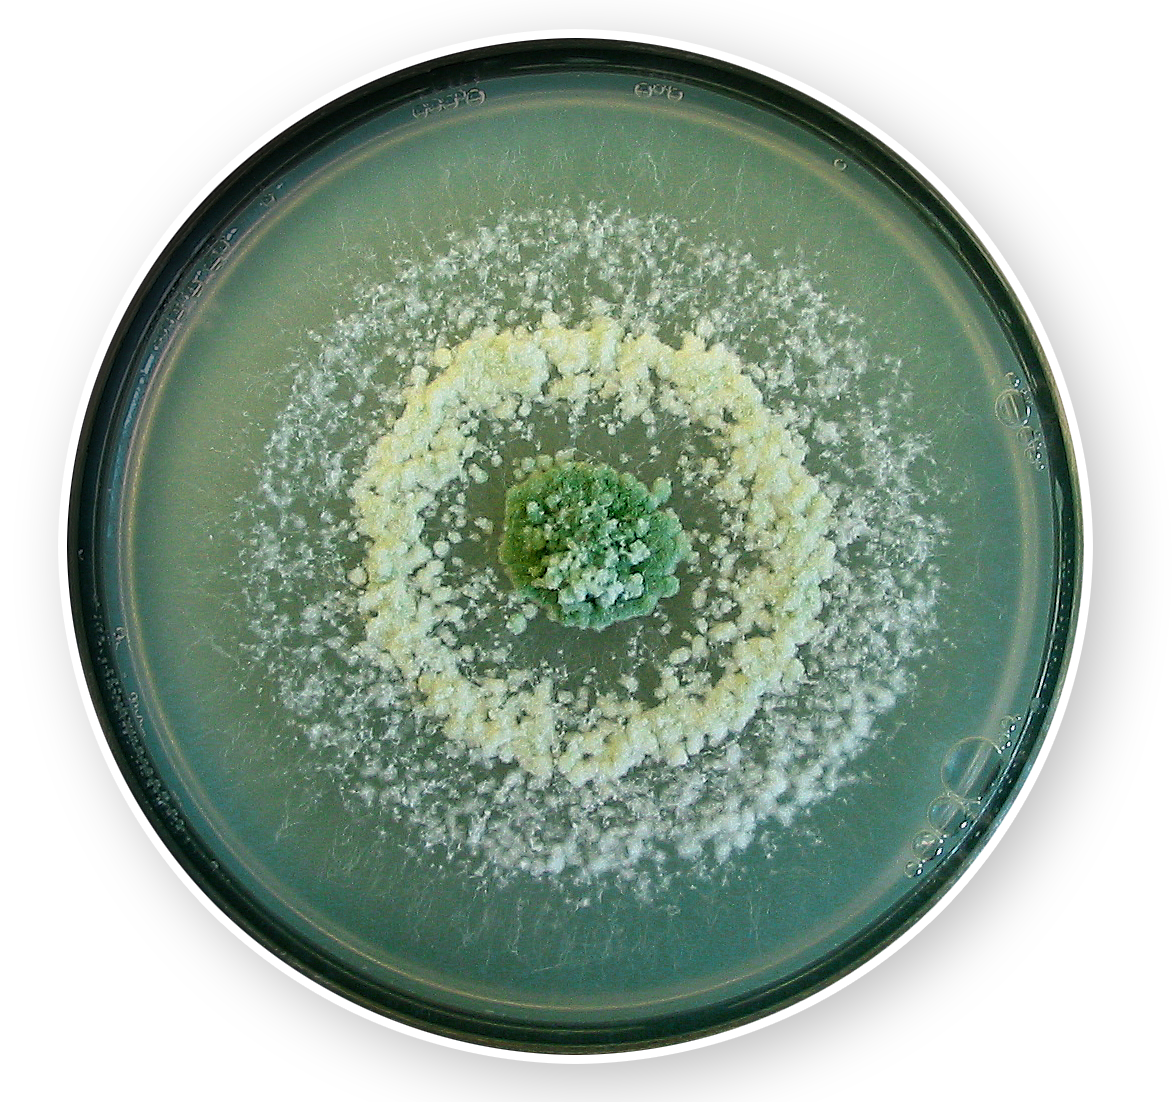

Abordando las enfermedades
para transformar la agricultura.
Biocontrol Technologies es una empresa dedicada al aislamiento, desarrollo, producción, registro y comercialización de insumos para mejorar la sanidad de los cultivos.
La misión principal de la compañía es ofrecer productos para el Control Integrado de las enfermedades de los cultivos agrícolas.